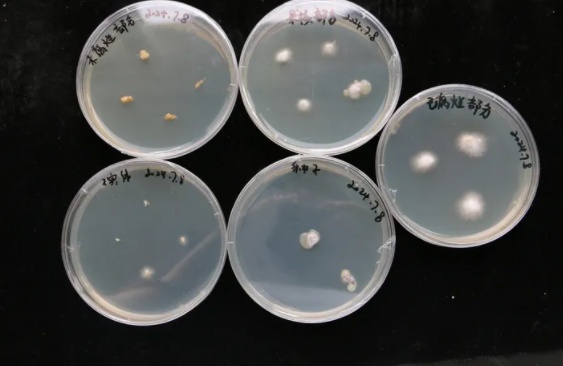
梅雨不断,苹果里长出了蘑菇?有人求购后尝了一口... 梅雨不断,苹果里长出了蘑菇?有人求购后尝了一口...

见过苹果生虫
也见过苹果长毛
但没想到
苹果里竟然还能长出蘑菇
emmm...这是真的
一女子家中有一个
放了一个多月的苹果
近日发现长出了白色蘑菇
被网友戏称为"果菌王"
一时间还成了"求菌若渴"的
科研人员的宝贝
苹果上长了白色蘑菇 邓小姐供图
上个月末,浙江梅雨不断。有一天早上,正准备出门上班的邓小姐发现,自己放在客厅塑料筐子里的一只苹果上长了"白毛"。因为忙,她忘记扔了,直到2天后才想起。
邓小姐拿起苹果一看
一朵雪白蘑菇
从苹果正中间的梗部长了出来
跨越2000多公里
"果菌王"寄到了昆明的实验室
"蘑菇长得挺好看,像把小扇子,还有波浪纹,用手轻轻碰了一下,硬度跟平时吃的白蘑菇差不多。"邓小姐全家人都觉得神奇,舍不得扔掉,她便把这只长着"高颜值"蘑菇的苹果暂时放到了厨房窗台。
由于厨房的光照更强,放了几天后,"果菌王"开始显得有些干瘪。但没想到,简单喷了点水,这朵蘑菇很快又舒展开。相比原先雪白的色泽,经历过这一番折腾后,蘑菇的颜色变得更黄了一些。
苹果上的白蘑菇 邓小姐供图
邓小姐将此事分享到网上
正是这无心之举
让"果菌王"命运的齿轮
开始转动
7月6日晚,在将"果菌王"挪到厨房窗台4天后,邓小姐收到中国科学院昆明植物研究所真菌多样性与分子进化课题组研究人员许博士的信息,他提出想购买这只长蘑菇的苹果。
"这个长蘑菇的苹果在我手里也没什么用,不如送给科研人员做研究还能发挥点价值。"邓小姐没有要许博士的钱,第二天便将长蘑菇的苹果通过快递寄去了昆明。跨越2000多公里,这只来自浙江德清的苹果到了中国科学院昆明植物研究所生物多样性实验室。
专家:这是裂褶菌
接下来将测其DNA
许博士介绍
苹果上的这种菌叫裂褶菌
也常被称为白参
是很著名的食用菌
"裂褶菌属于木腐生菌,像腐木、公园木扶手、木地板等位置,都是它喜欢生长的地方,但生长在新鲜水果上的不常见。"许博士说,自己见过从桃子、柿子等水果上长出来裂褶菌,但在国内还未见过像从苹果上长出来的情况。1970年有外国学者做过实验,将裂褶菌菌丝接种到苹果上面,且成功长出了子实体。
在他看来,前段时间,浙江一直处于梅雨天气,温度和湿度都比较高,正是非常适合裂褶菌生长的条件。
许博士说,一般情况下,裂褶菌都是通过分解附着物上的木质素获得营养,像苹果这样的生长条件,往往很难满足其生长需求。
前几天。许博士将苹果切开后。及时向网友们汇报了进展情况:"白参菌丝已经完全侵染整个苹果;苹果未腐烂果肉部分有少量菌丝生长;已腐烂果肉部分的菌丝长得最快,这说明白参主要营养来源就是腐烂的果肉……"
苹果切开后的情况 许博士供图
那苹果白参味道如何?"我刚尝了一口,没啥特别的味道。"许博士说,要长出苹果味的白参可能性较小。其特殊风味主要来自自身氨基酸及一些特殊的化学物质,白参风味不大可能受苹果影响。
目前,许博士已将这只长蘑菇的苹果分开接种培养,预计两个月后,便可以开始进行人工栽培实验,长出更多"果菌王"。
从苹果不同部位分离的白参菌丝生长情况 许博士供图
"裂褶菌属全球大约有11个物种,根据中国生物多样性2024版可知,中国分布有5种左右。接下来,我们打算测一下苹果上的这朵裂褶菌DNA序列,看看它到底属于哪个物种。"
许博士说,白参有很大的栽培价值和经济价值,该菌株仅靠很少的基质就能保持如此长势,可以为日后白参菌种选育提供一定参考。因此,后续他考虑通过与其他菌种杂交的方式,探索选育性状更优良的白参菌种。
"果菌王"评论区一片欢乐
看到"果菌王"的经历
有网友感叹其终于
发挥科研价值
"可以申请一个课题
做一个研究"
也有网友发挥了创造力
"苹菇"
"下次自己吃了
常常啥味儿"
综合自潮新闻、网友评论
来源: 新闻坊